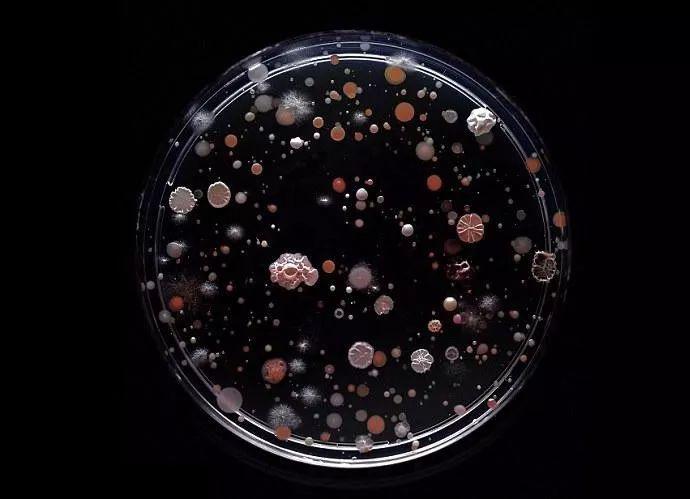

有这么一部剧
满怀期待等了3年多
结果被买到狗血淋头
对,我说的就是——舌尖上的中国三!
第一季豆瓣9.7的高分
第三季直接掉到了4.1分???
为什么?
这一切的背后究竟是道德的沦丧还是人性的扭曲??
有一大部分是因为那个回国学中医药,和同学们一起自制中药口红的移民姑娘
↓↓↓
用到的制作中药口红的材料被网友扒出是购自淘宝三无店……这就算了,连手套都不带,不怕有细菌咩?咩咩咩???
虽然姑娘表示这些并不会出售,但是这满屏的三无微商既视感,不知道的还以为这是哪个假货作坊呢!
这一段真是看得芽芽想跳脚,无论是彩妆还是护肤品,都一定要买经过严谨研发、正规生产、卫生合规、资质齐全的产品!
芽芽今天就带大家来了解一下
有哪些不靠谱的彩妆护肤品!
不想烂脸就要谨慎了!
↓↓↓
正规品牌的妆品里,总是会添加防腐剂的。而那些号称无添加防腐剂的产品,是要做到非常严格的杀菌和无菌处理。不然糊你脸上的就不是化妆品,而是细菌培养皿了!
而私人自制,是没办法做到这么严格的环境要求的。
就算原材料有经过细心挑选,也没法保证制作过程里不会产生细菌或者微生物。
淘宝上一搜一大堆的手工自制纯天然化妆品,号称不添加任何化学成分,纯植物提取,无铅汞,孕妇都能用,绝对安全……但谁能保证细菌不超标,谁说纯植物就能不过敏?谁能保证??毕竟这些东西可没有质检部门的监督哦~
如果你热爱DIY,就是做出来自用或者送送亲朋好友,那么你也要小心了~
举个栗子,自制里最火的面膜,淘米水、珍珠粉、黄瓜皮……
虽然珍珠粉是化妆品广泛使用的原料,但是直接涂抹在皮肤表面,并没啥效果,而需要提取它的有效成分,合理配比后制成产品才能发挥它的功效哦~
很多人一味觉得乳化剂等化学成分会刺激皮肤,对皮肤不好。觉得可以吃的食物才是纯天然对皮肤无害的,其实这都化学课没有好好听的结果啊!
化学不等于有害,可以吃的食物也不一定就适合涂抹皮肤上。
果蔬、中草药等虽是纯植物,不含任何防腐剂和化学成分,但直接敷上脸,很容易造成刺激、发红等过敏症状。
再想想你制作过程中植物产生的汁液给细菌提供了多丰富的营养,细菌们简直爽得吱哇乱叫。
这样的产品涂抹到脸上,你能放心?万一涂在有破损的皮肤上,不感染就谢天谢地啦~
为什么那么多人在买微商护肤化妆品呢?很多刚开始涉足美妆护肤的小白,是很容易受蒙蔽的。
当她们看到了微商的朋友圈,发现:
哇!这个效果很不错喔!
那么贵质量肯定非常好喔!于是就傻乎乎地入坑了……
殊不知,大品牌的护肤品,它的生产标准经过层层质检。
而很多微商产品是没有备案的,产品成分很多是不合格不合法的,所以它的东西用完以后你可能会过敏、烂脸甚至皮肤会出现依赖性。
而且出现问题之后想维权?难了!
之前张庭拼命在微博上吆喝的TST活酵母,声称纯天然无添加,孕妇都可以使用的活酵母,利用明星效应可是火了一把。
活酵母???
酵母菌属于真菌,活着的酵母菌可是会繁殖并导致产品变质的!
且不管是否添加了活酵母,当用户使用后发现过敏问题时,TST销售人员还是会让坚持使用。说什么“出现皮肤不适就是排毒,TST没有问题,有问题的是你之前用了含有激素的产品balabala”。
出问题了不停用去看医生,是怕脸烂的不够快吗!即使产品本身没问题,也不排除用户可能对某一成分过敏。这种误导和不负责任的行为,也是导致很多人烂脸的元凶。
当然,这也不是一竿子打死所有微商,毕竟每个行业多少都有老实人,但是谁愿意当小白鼠去试水?
买微商买到好货几率约等于中彩票,何苦要拿自己的宝贝脸去赌呢?
对,你没看错,不止衣服能打板,现在连化妆品护肤品都有人打板了。
虽然大牌妆品能查到配方,但是人家配方比例是保密的啊!
衣服一比一打板就算了,即使布料细节没办法一模一样,穿在身上的东西不至于出什么事。但现在连涂在脸上的东西都敢打板?
是否合法获得了配料表?是否真的以原产品的配料以及比例调制?比例做了调整?怎样的调整?是否做过一系列测试?……
而且,化妆品需要有质量合格证,生产日期,生产厂家,才不算三无。而之前有个玩打板的网红,自己也说过不能公布供应商和生产商名字。
根据《中华人民共和国产品质量法》规定必须有中文厂名,中文厂址、电话、许可证号、产品标志、生产日期、中文产品说明书、如有必要时还需要有限定性或提示性说明等等,凡是缺少的均视为不合格产品!不合格产品!还要芽芽再重复一遍吗??

芽芽之前也经常在淘宝买分装来使用,特别是粉底。几百上千块钱的粉底液,色号那么多,不可能一瓶一瓶买回来试,而且不试怎么知道它的肤感妆感持久度适不适合自己?
网上功课仅供参考,还是买分装来试更可靠。
但是分装被淘宝禁售了!为什么要禁这种造福我等贫苦大众的好事情?
因为除了可能出现假货、以次充好这些问题以外,还有一大问题,和自制化妆品类似,那就是微生物超标!
曾经做过配方师的三亩叔说过,包装大改小,随着包装变小,同样1ml产品和包装材料接触的面积变大了。就容易产生微生物超标,还有更复杂的相容性问题。
就比如有些只能装玻璃瓶的产品,被装进了塑料瓶,可不能保证产品不和包装搞点什么乱七八糟的事情,导致一些什么说不清的后果了。
但我们自己出门也经常需要把妆品放分装瓶里携带,这样不是也会出问题吗?
芽芽只能说,控制数量,尽快用完吧!
分装时还有三点要关注:
1、含有不稳定成分的产品不建议分装
2、分装瓶要选择玻璃或者PP(聚丙烯)材料
3、分装的包材要消毒(在沸水里煮或者用75%的酒精擦拭晾干)
小芽爱叨叨:
长得丑还能靠整形
而用坏产品烂脸医生都不一定救得了你!
都来说说年少无知的你
曾经被什么东西坑害过吧
(不仅限于妆品哦~)
大家还爱看
点赞的北鼻
都能月入好几万
化妆品随便买!
↓↓↓